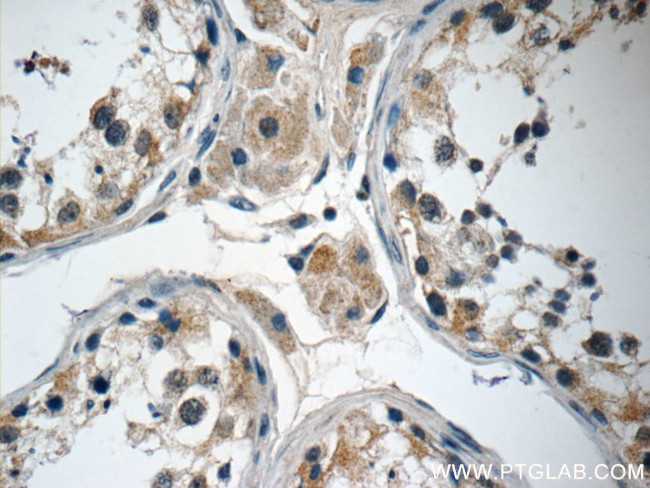
ANKRD33 Antibody in Immunohistochemistry (Paraffin) (IHC (P))

Search
Proteintech
ANKRD33 Polyclonal Antibody
{{$productOrderCtrl.translations['antibody.pdp.commerceCard.promotion.promotions']}}
{{$productOrderCtrl.translations['antibody.pdp.commerceCard.promotion.viewpromo']}}
{{$productOrderCtrl.translations['antibody.pdp.commerceCard.promotion.promocode']}}: {{promo.promoCode}} {{promo.promoTitle}} {{promo.promoDescription}}. {{$productOrderCtrl.translations['antibody.pdp.commerceCard.promotion.learnmore']}}
产品信息
25202-1-AP
种属反应
宿主/亚型
分类
类型
抗原
偶联物
形式
浓度
规格
纯化类型
保存液
内含物
保存条件
运输条件
产品详细信息
Immunogen sequence: AMRNRCECV ATLLMAGADL TAVDPVRGKT ALEWAVLTDS FDTVWRIRQL LRRPQVEQLS QHYKPEWPAL SGLVAQAQAQ AQVAPSLLER LQATLSLPFA PSPQEGGVLD HLVTATTSLA SPFVTTACHT LCPDHPPSLG TRSKSVPELL VPAEAQSFRT PKSGPSSLAI PGAQDREEET GGGGQNGTEV GEDGIGQAGN R (73-272 aa encoded by BC121153)
靶标信息
Ankyrin repeat domain 33 (ANKRD33), also named as C12orf7, belongs to the ankyrin repeat family and is highly expressed in retina. ANKRD33 exists as two isoforms. The isoform 1 molecular weight is 29 kDa and isoform 2 is 49 kDa. The function of ANKRD33 is still non-known.
仅用于科研。不用于诊断过程。未经明确授权不得转售。
篇参考文献 (0)
生物信息学
蛋白别名: Ankyrin repeat domain-containing protein 33; Photoreceptor ankyrin repeat protein; unnamed protein product
基因别名: ANKRD33; C12orf7; PANKY
UniProt ID: (Human) Q7Z3H0
Entrez Gene ID: (Human) 341405